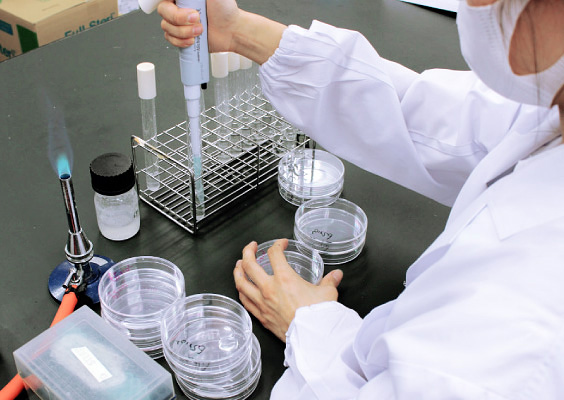

エムテック衛生検査所
マルマの総合衛生サービスを支える。
エムテック衛生検査所は、各種検査業務を行う他、マルマ独自の総合衛生管理メソッド「M-TEC」の要となる施設です。
エムテック衛生検査所の役割
エムテック衛生検査所には、検査施設としての側面と、マルマの独自サービスの研究・開発を行う研究所としての側面があります。特に後者においては、昆虫の生態を研究することにより薬剤や防除・駆除手法の最適化を進める他、社内に在籍する各分野の専門家の知見や最新知識をいったん集約し、教材として社内に再分配するなど、マルマのサービス品質全体を引き上げる役割を果たしています。

コンサルティング

食品業界をはじめとするさまざまな業界で培った知見を、お客様に還元。HACCP、ISO22000の取得支援をはじめ、ソフト面・ハード面が両立した衛生管理体制を根付かせ、持続的なレベルアップをサポートするコンサルティングサービスを行っています。
検査業務
水質検査

主に、特定建築物の管理者や井戸水を利用している個人を対象として、法定検査や水の安全性を確認するための検査を行っています。pH、色度、濁度、イオン類(硝酸態窒素、塩化物イオン)、金属、有機炭素量、消毒副生成物等の定量分析を行っています。簡単な手分析から操作の難しい機器分析までさまざまな分析法を実践しています。
検便検査

主に、調理従事者や乳幼児・高齢者と接する方を対象に、腸内細菌(O157、赤痢菌、サルモネラなど)の保菌検査を行っています。精度の高い確実な検査で食中毒・感染症リスクの低減に貢献します。ノロウイルス検査では検査精度と緊急性を考慮し、最適な検査方法(リアルタイムPCR法、イムノクロマト法等)をお選びいただけます。
虫・異物検査

製品に混入した異物を食品工場や金属製造工場などに設置したトラップに捕獲された昆虫を同定し、生息している昆虫の特性から製造環境の問題点を指摘し、対策提案を行います。
また、商品に混入した異物鑑別も実施しています。虫の同定の他、カビ・植物・毛・鉱物・原料の変質した物質などを調査いたします。
また、商品に混入した異物鑑別も実施しています。虫の同定の他、カビ・植物・毛・鉱物・原料の変質した物質などを調査いたします。
食品検査
食中毒や食品の変質を防止するためには、定期的な微生物検査による安全性・品質を検証することが必要です。そのため、御依頼いただいた食材や調理品に付着している大腸菌や黄色ブドウ球菌など食中毒の原因菌となる微生物や、微生物汚染の指標となる一般生菌数や大腸菌群数の検査を実施しています。
また、新商品の賞味期限を決定するための日持ち検査や直接製造現場に入って目視点検・環境拭き取り検査も実施しています。
また、新商品の賞味期限を決定するための日持ち検査や直接製造現場に入って目視点検・環境拭き取り検査も実施しています。
設備機器一覧
検便検査

サーマルサイクラー
_.jpg)
リアルタイムPCR(新型)
_.jpg)
リアルタイムPCR(旧型)

安全キャビネット

自動懸濁装置

卓上遠心分離機
食品検査

インキュベーター

オートクレーブ

コロニーカウンター

ストマッカー

リアルタイムPCR
_.jpg)
自動秤量希釈装置(ダイリューター)
水質検査

pH・色度・濁度自動測定装置

TOC計

ウォーターバス

ドラフト
_.jpg)
パージトラップ ガスクロマトグラフ
質量分析計(PT-GCMS)
質量分析計(PT-GCMS)
_.jpg)
ヘッドスペース ガスクロマトグラフ
質量分析計(HS-GCMS)
質量分析計(HS-GCMS)

ホットスターラー

固相カラム自動乾燥装置

固相抽出装置

自動洗浄機

水銀測定装置

超純水製造装置

分光光度計
_.jpg)
誘導結合プラズマ質量分析計(ICPMS)
シアン・臭素酸分析用_.jpg)
液体クロマトグラフ(LC)
シアン・臭素酸分析用
シアン・臭素酸分析用
陰イオン界面活性剤、非イオン界面活性剤用_.jpg)
液体クロマトグラフ(LC)
陰イオン界面活性剤、
非イオン界面活性剤用
陰イオン界面活性剤、
非イオン界面活性剤用
陰イオン用_.jpg)
液体クロマトグラフ(LC)
陰イオン用
陰イオン用
虫異物検査
_.jpg)
フーリエ変換赤外分光光度計(FT-IR)
_.jpg)
顕微鏡(左:生物顕微鏡、右:実体顕微鏡)